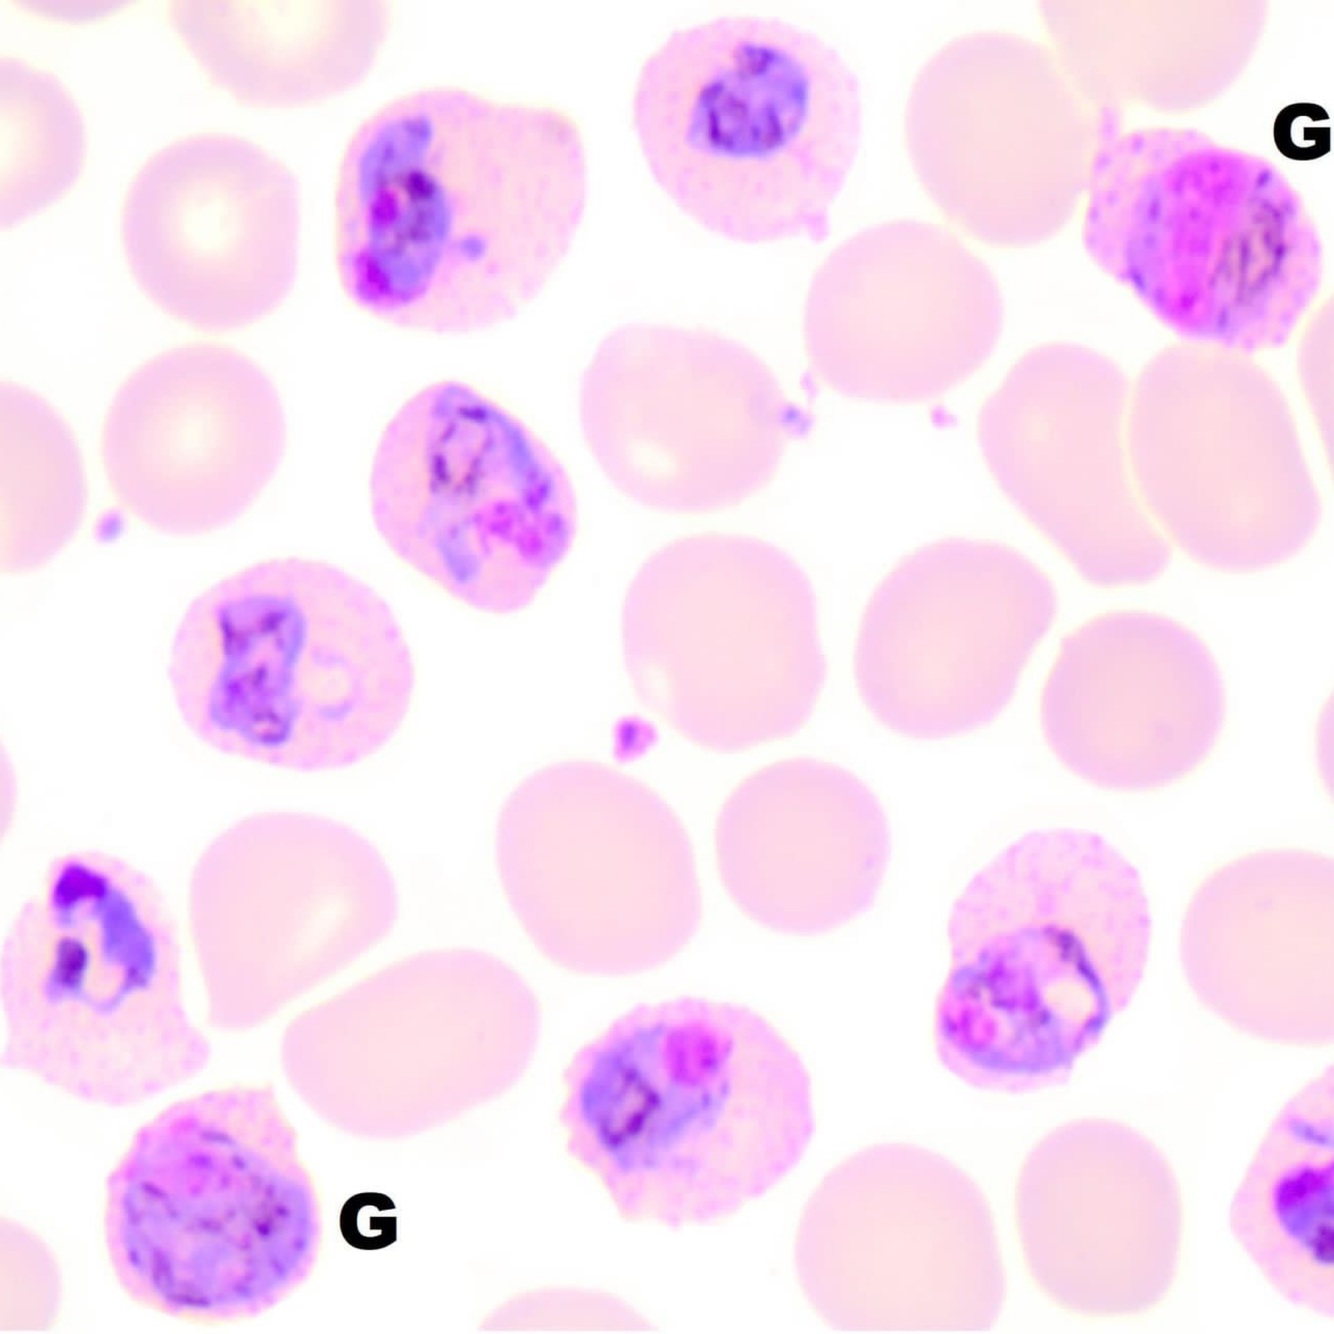
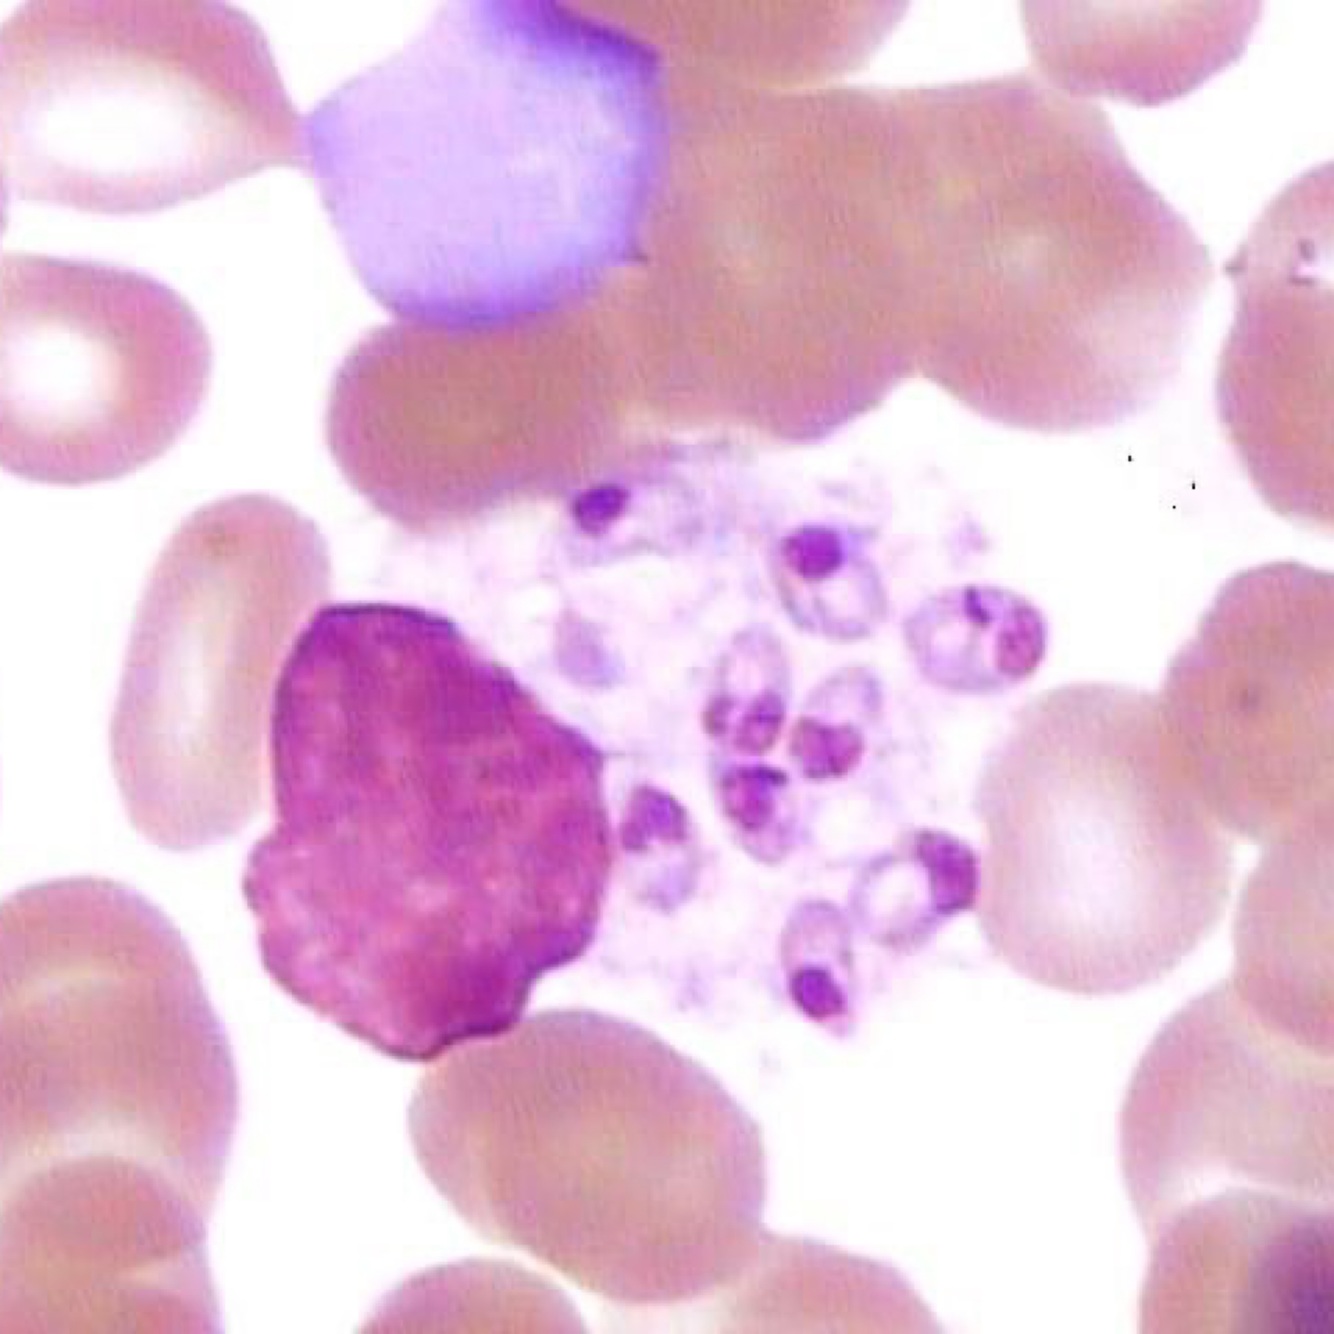
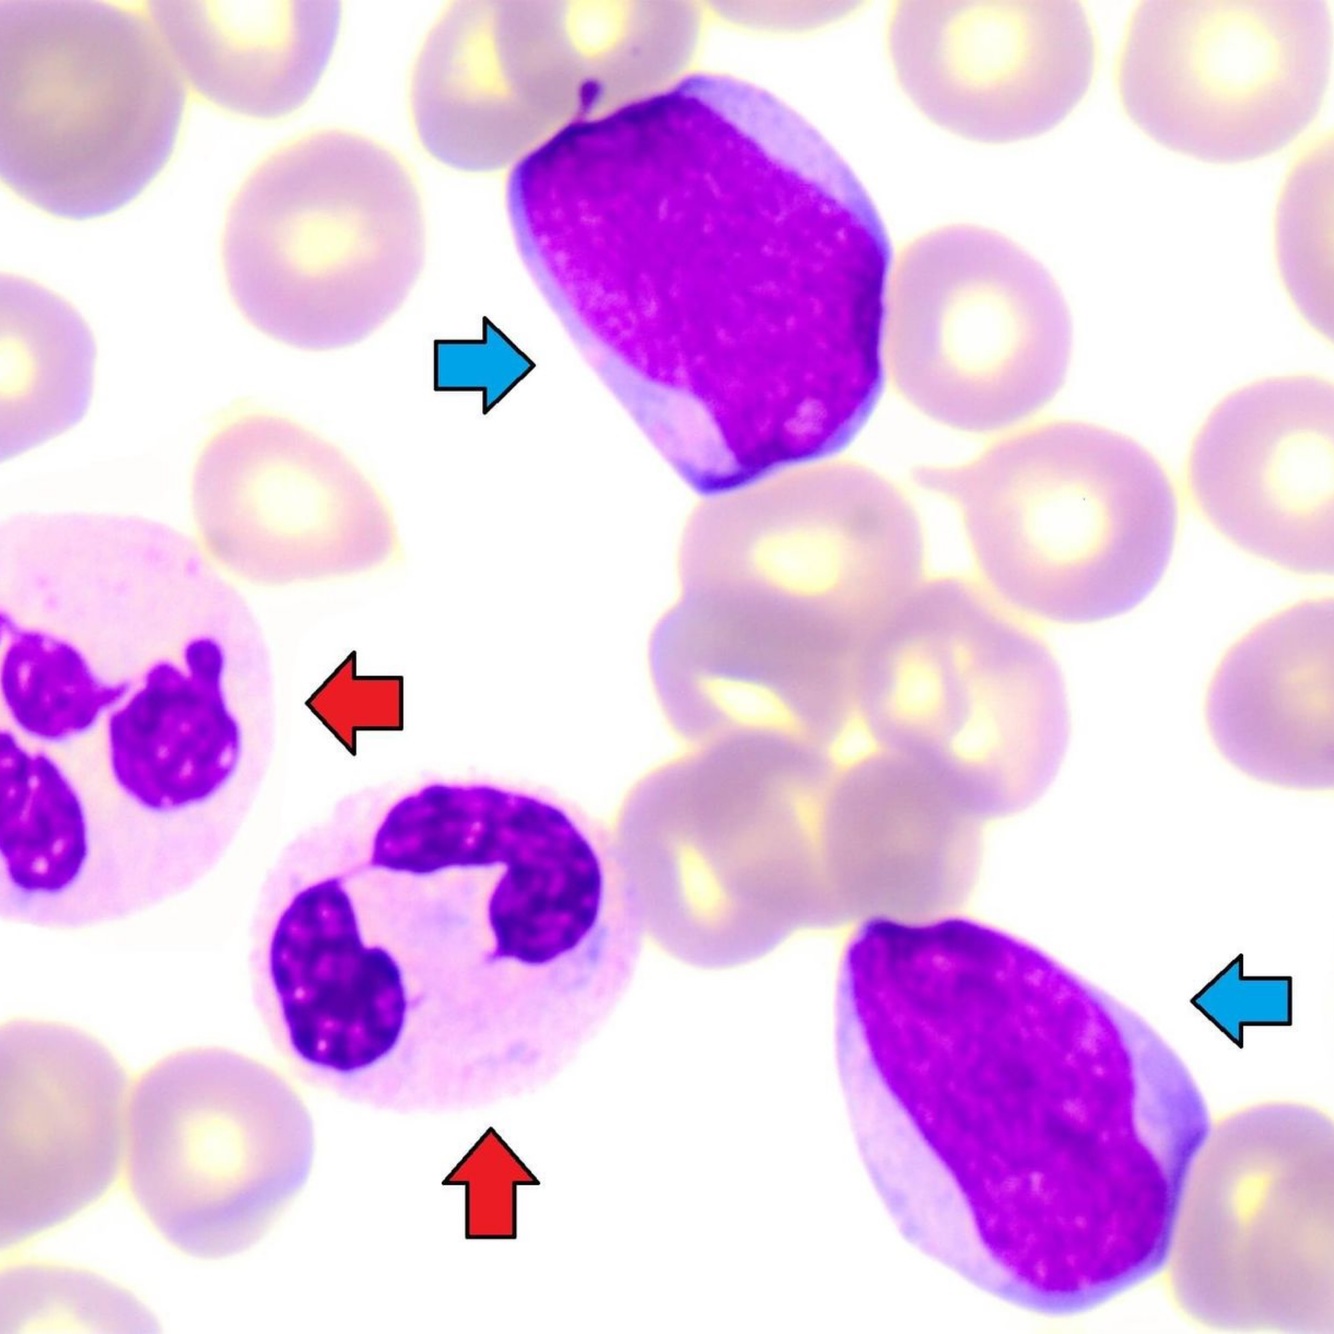
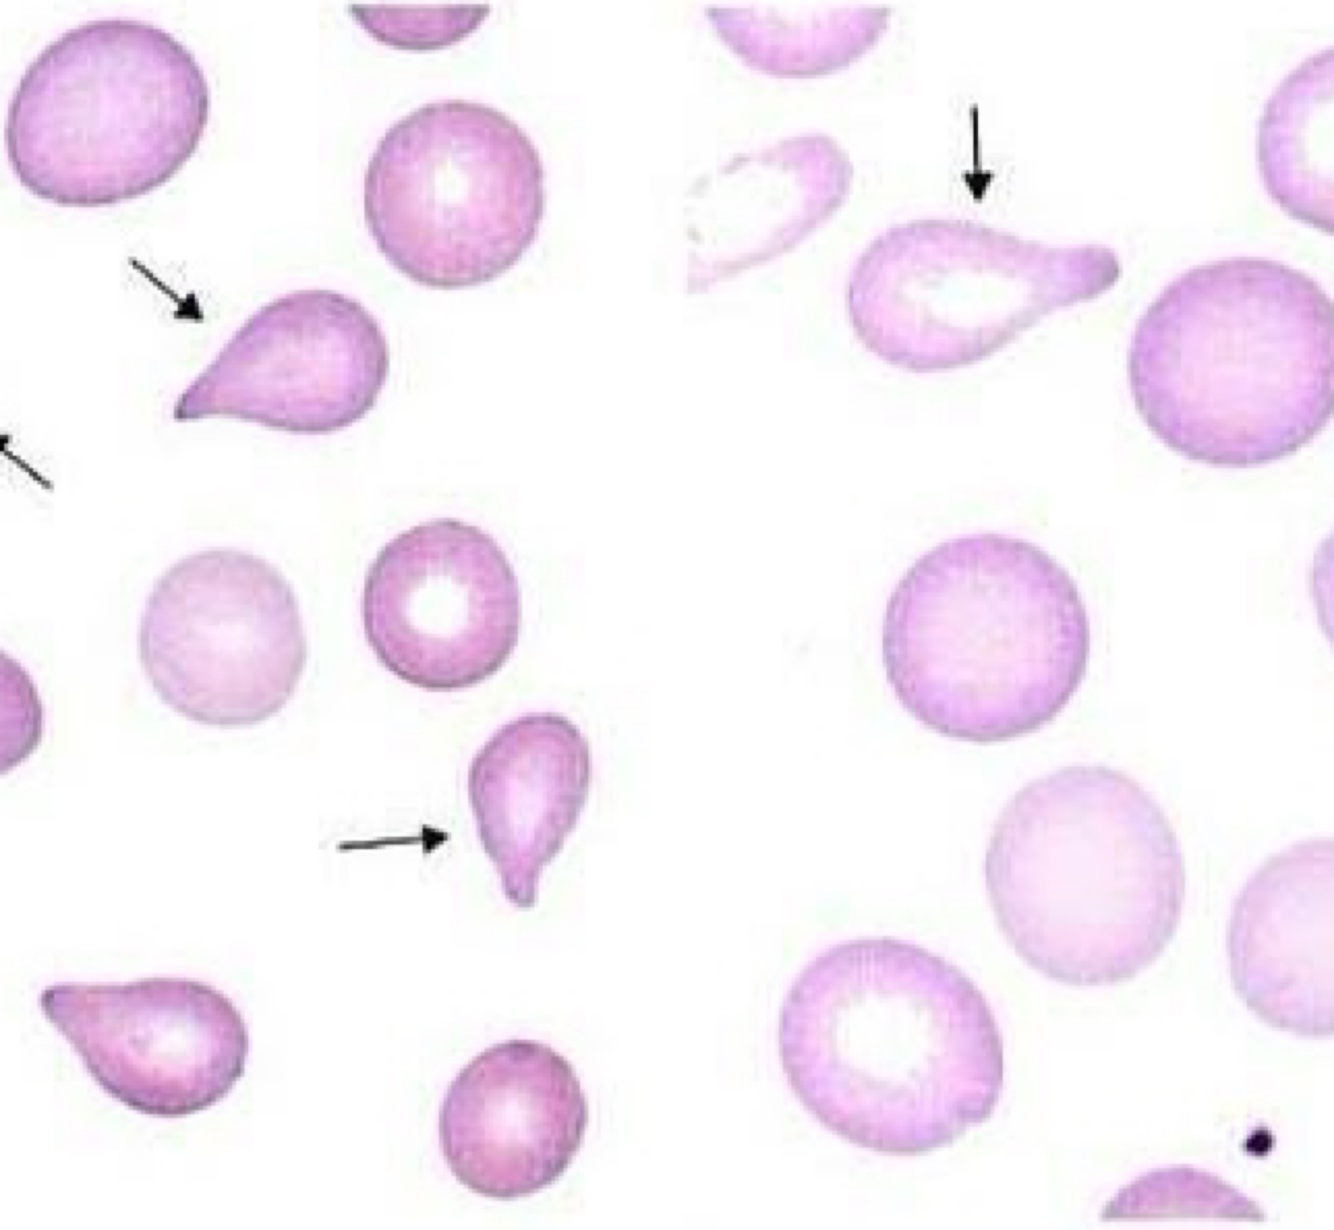
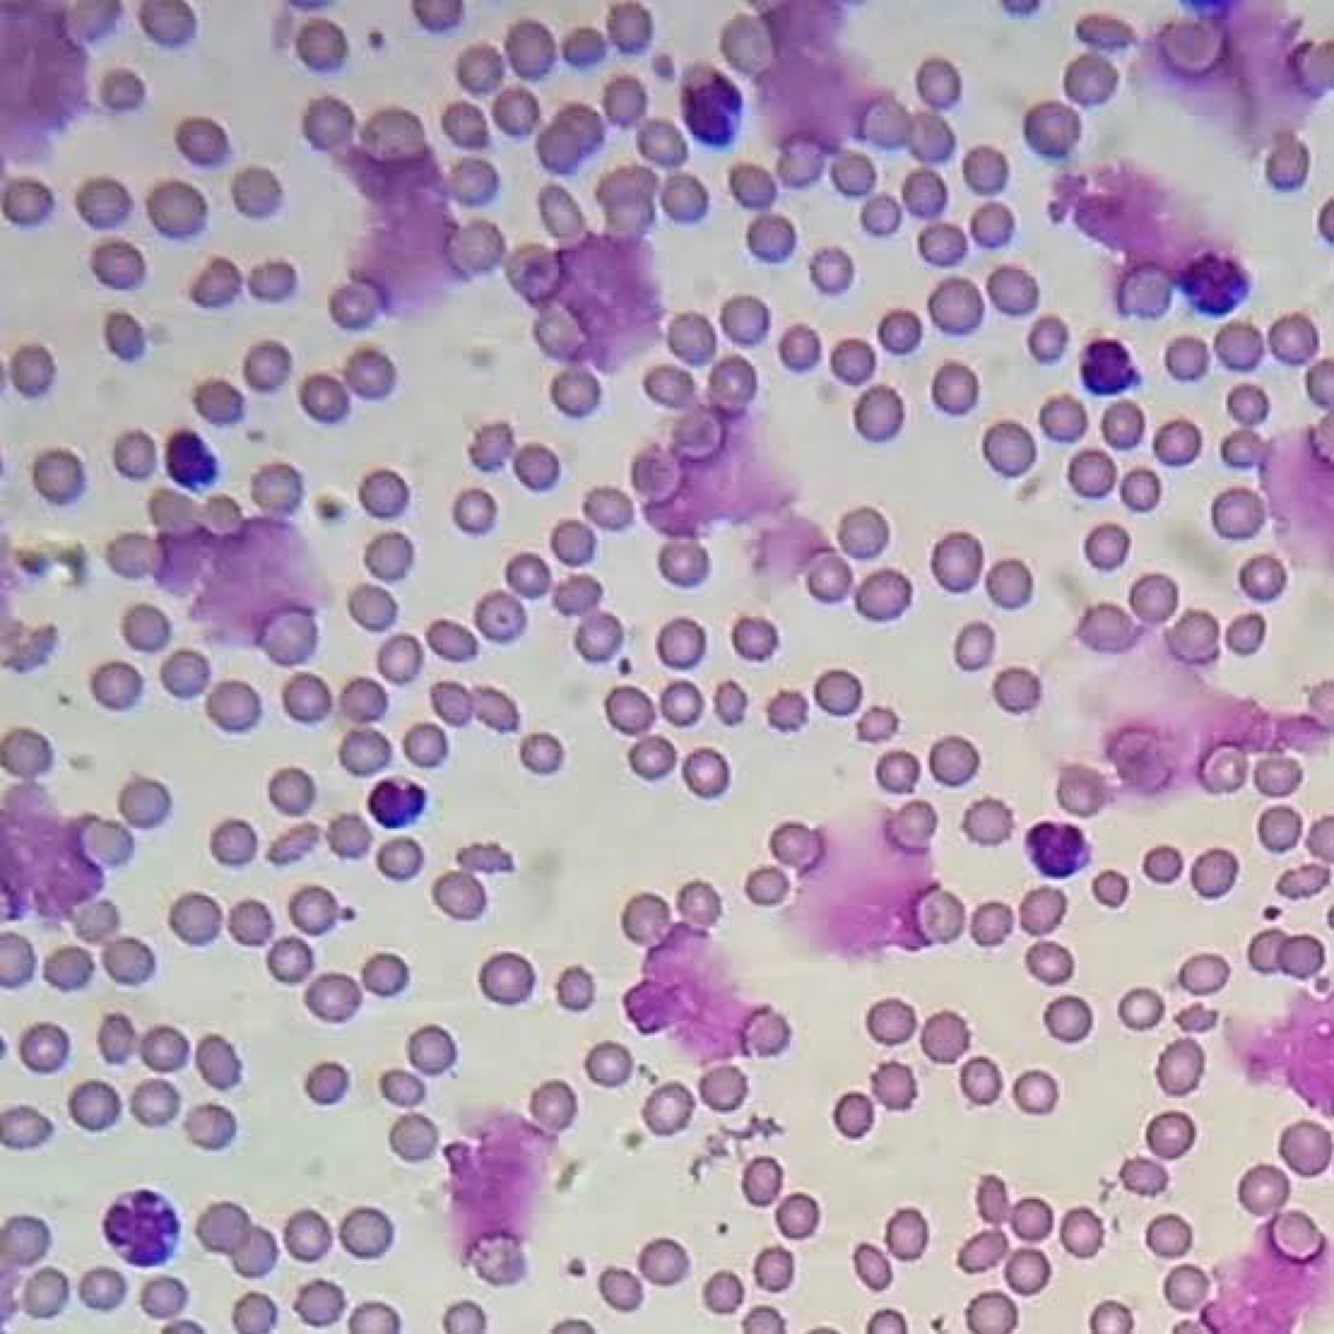
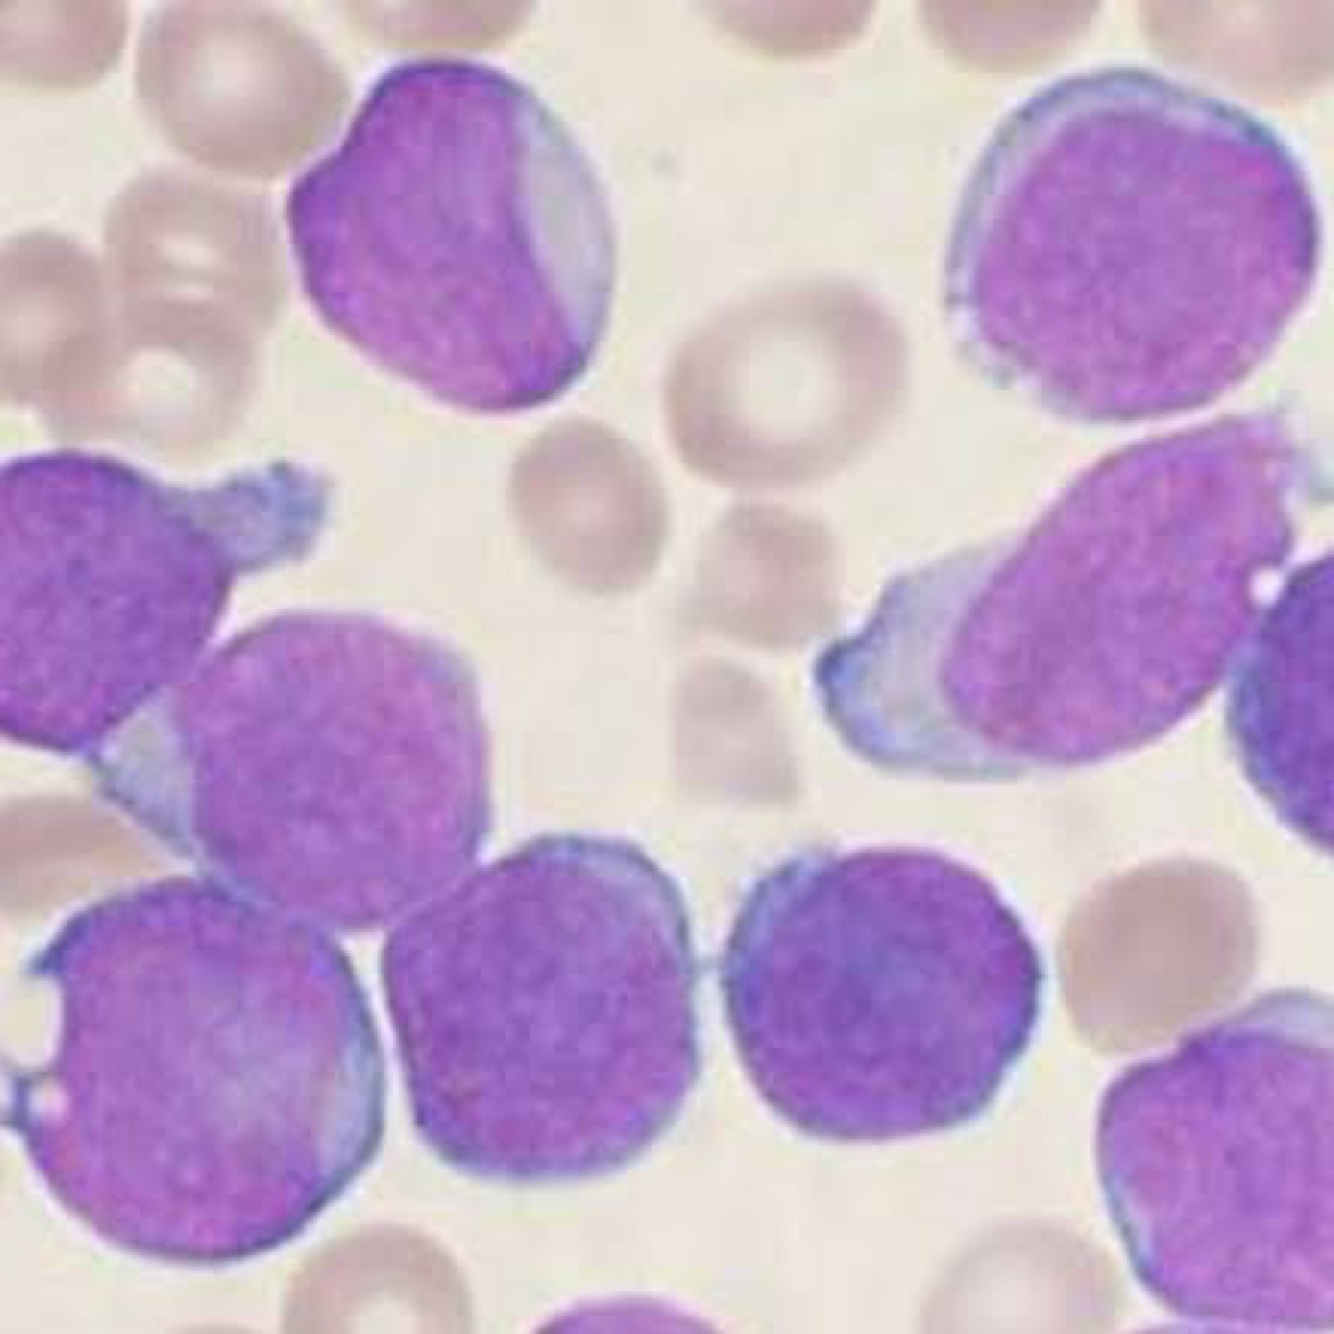
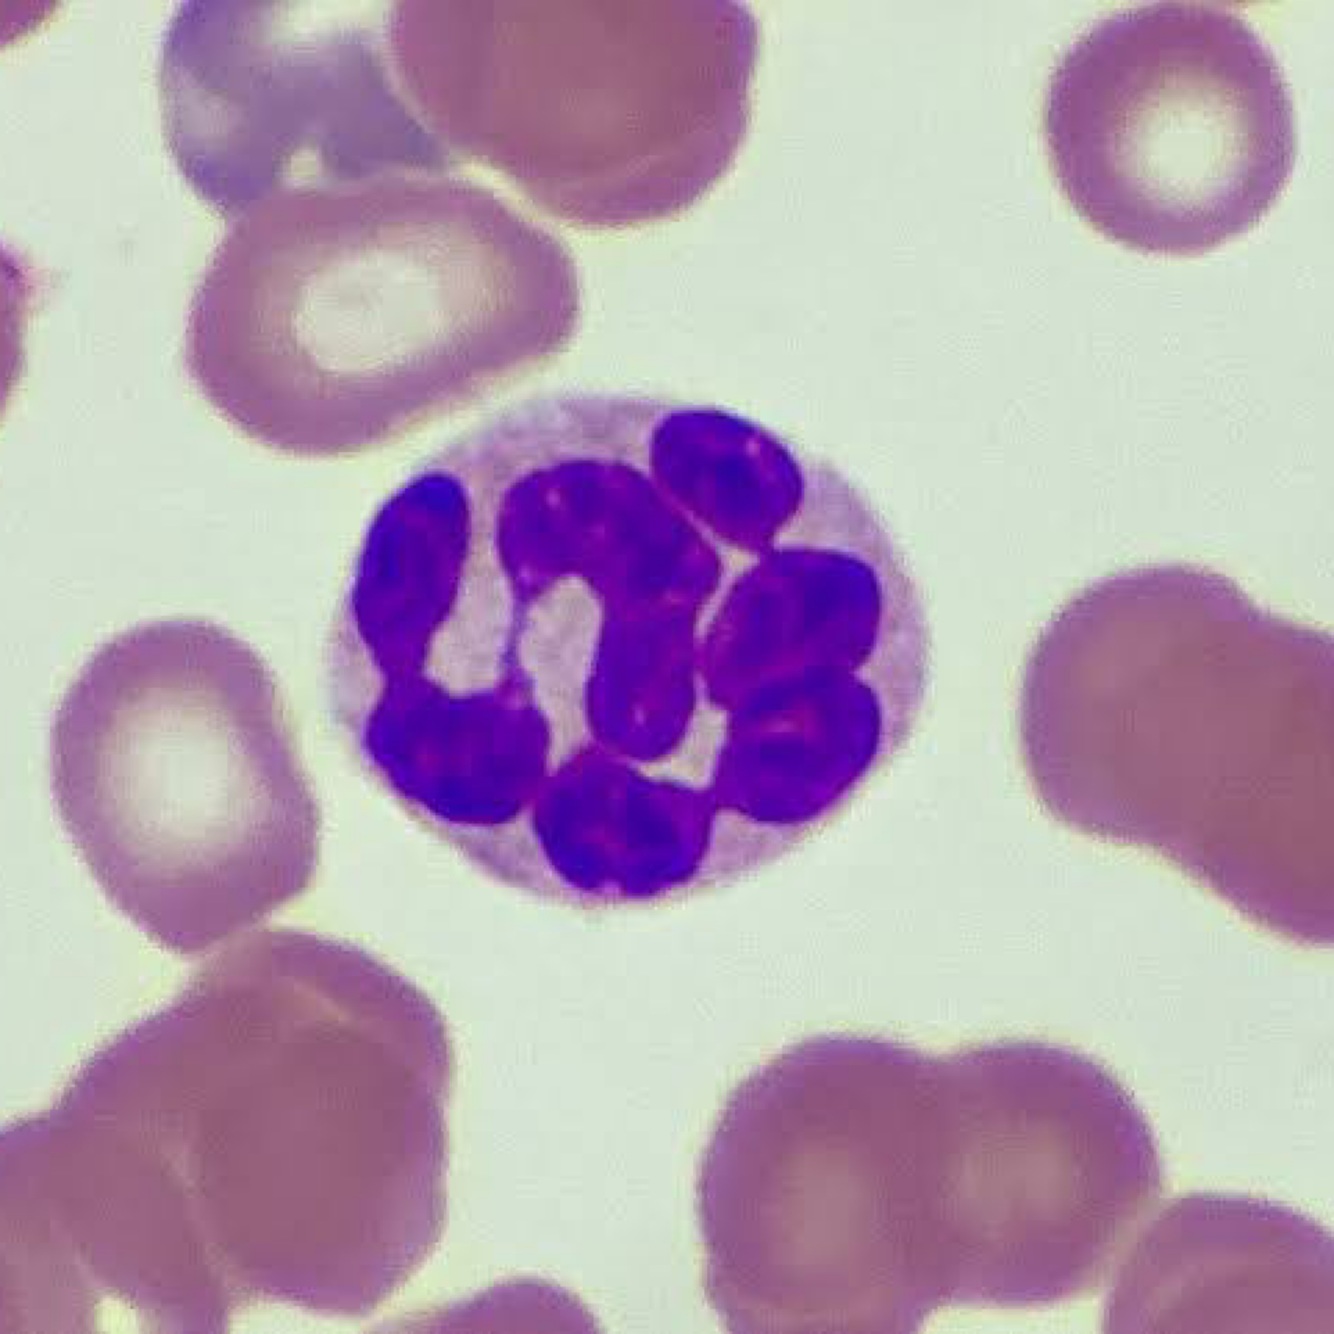
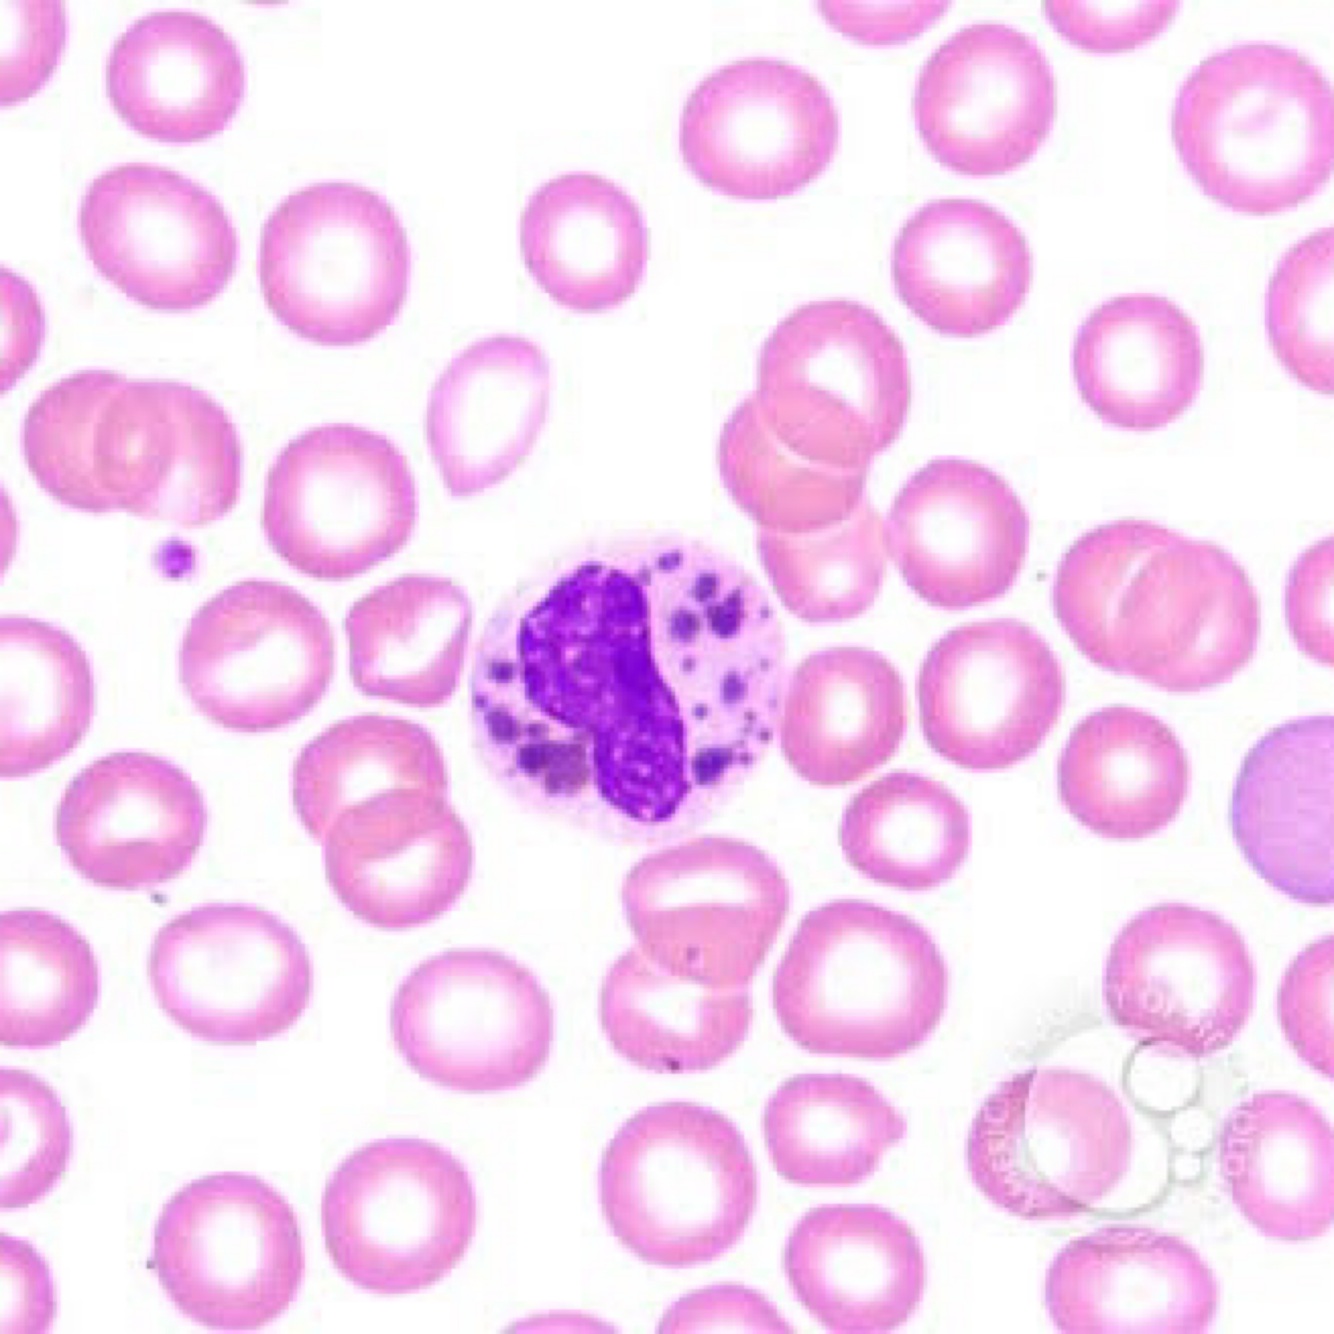
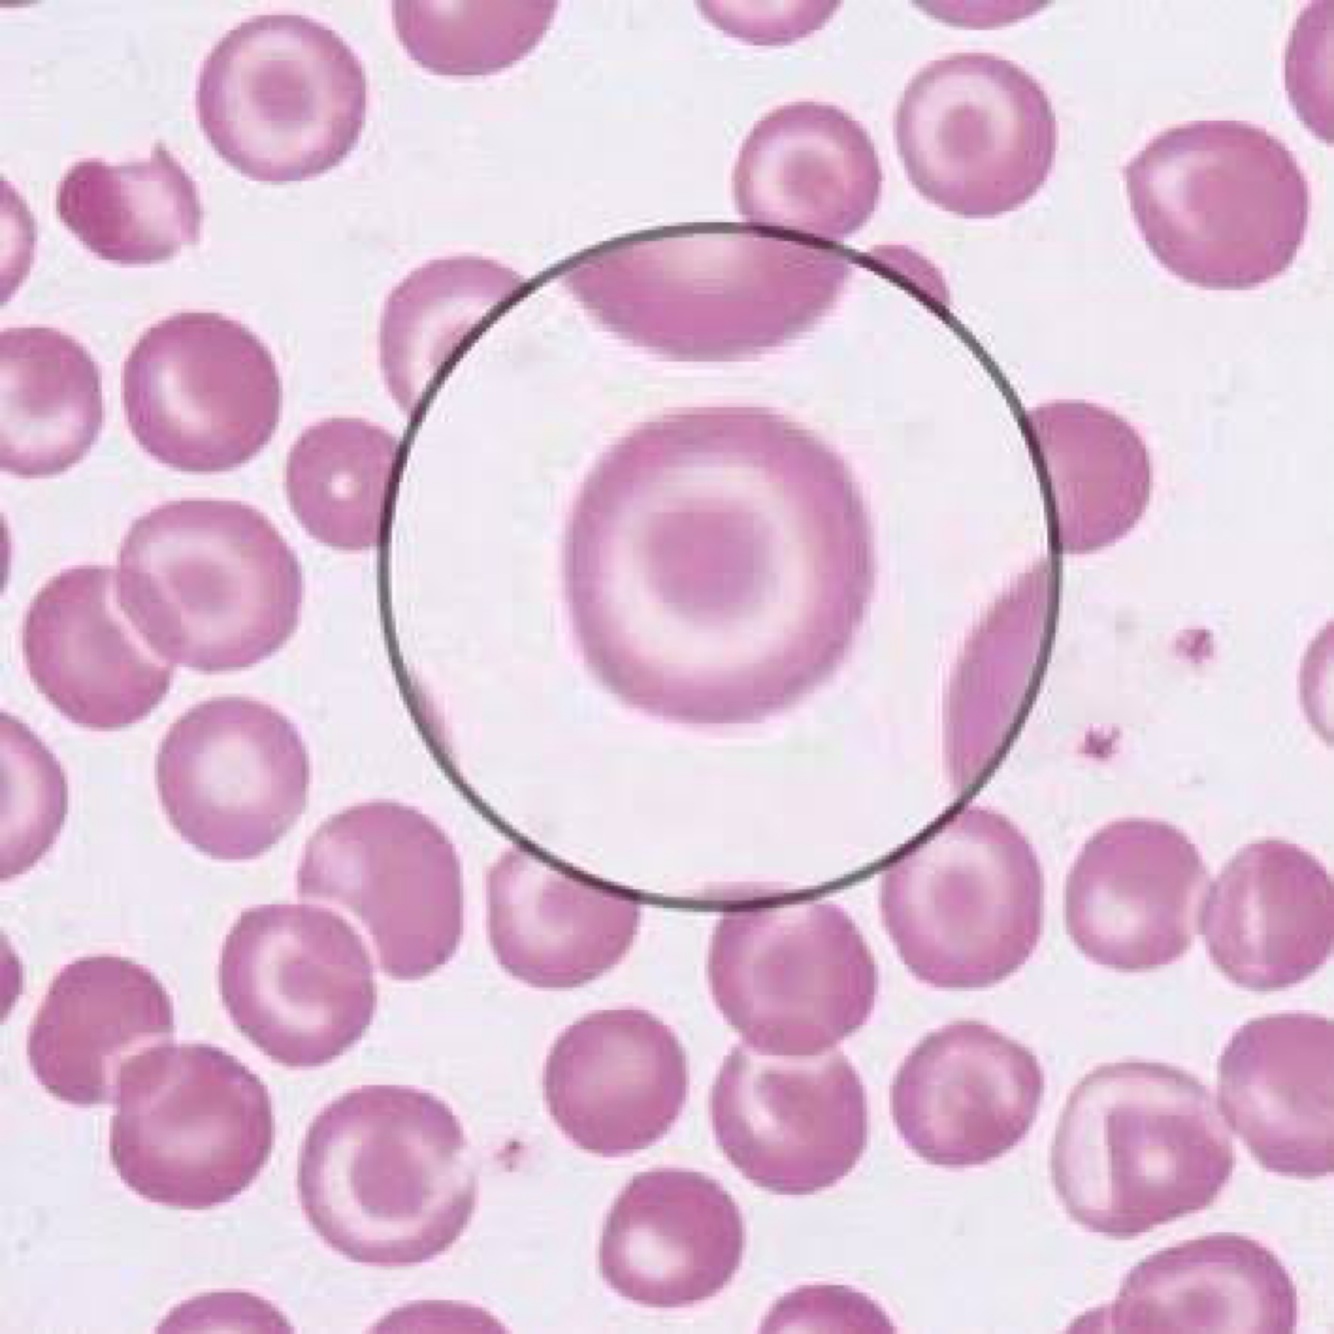
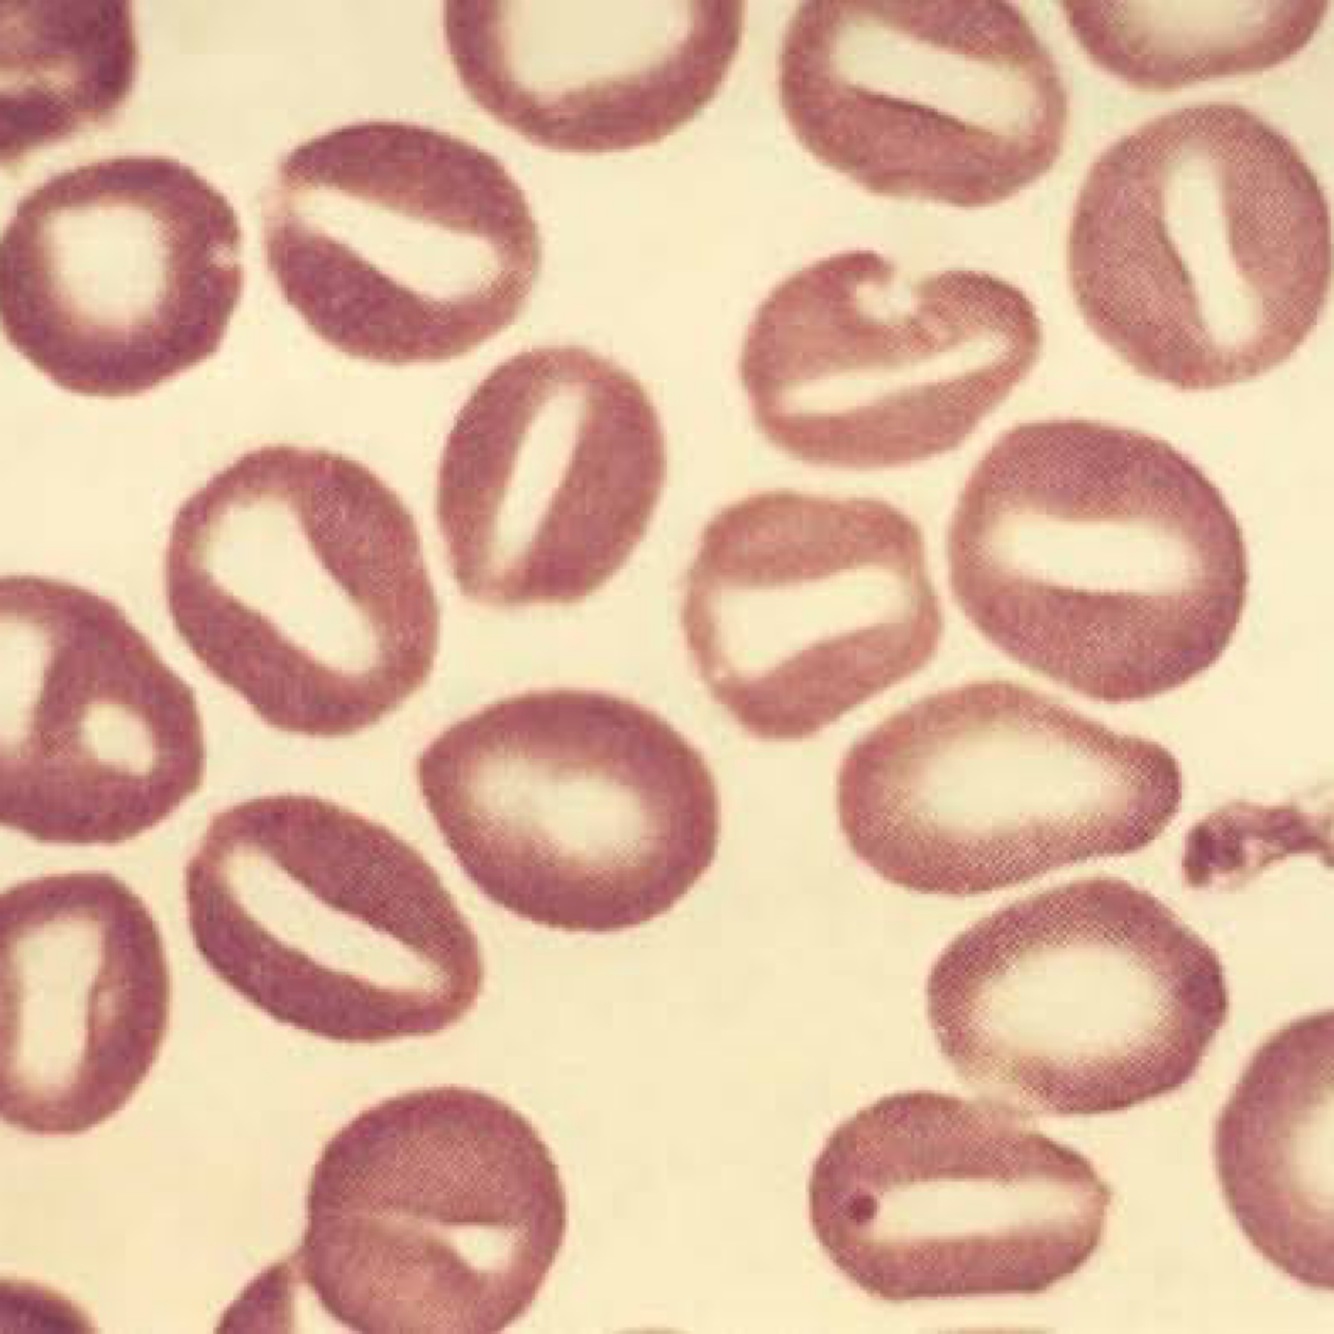
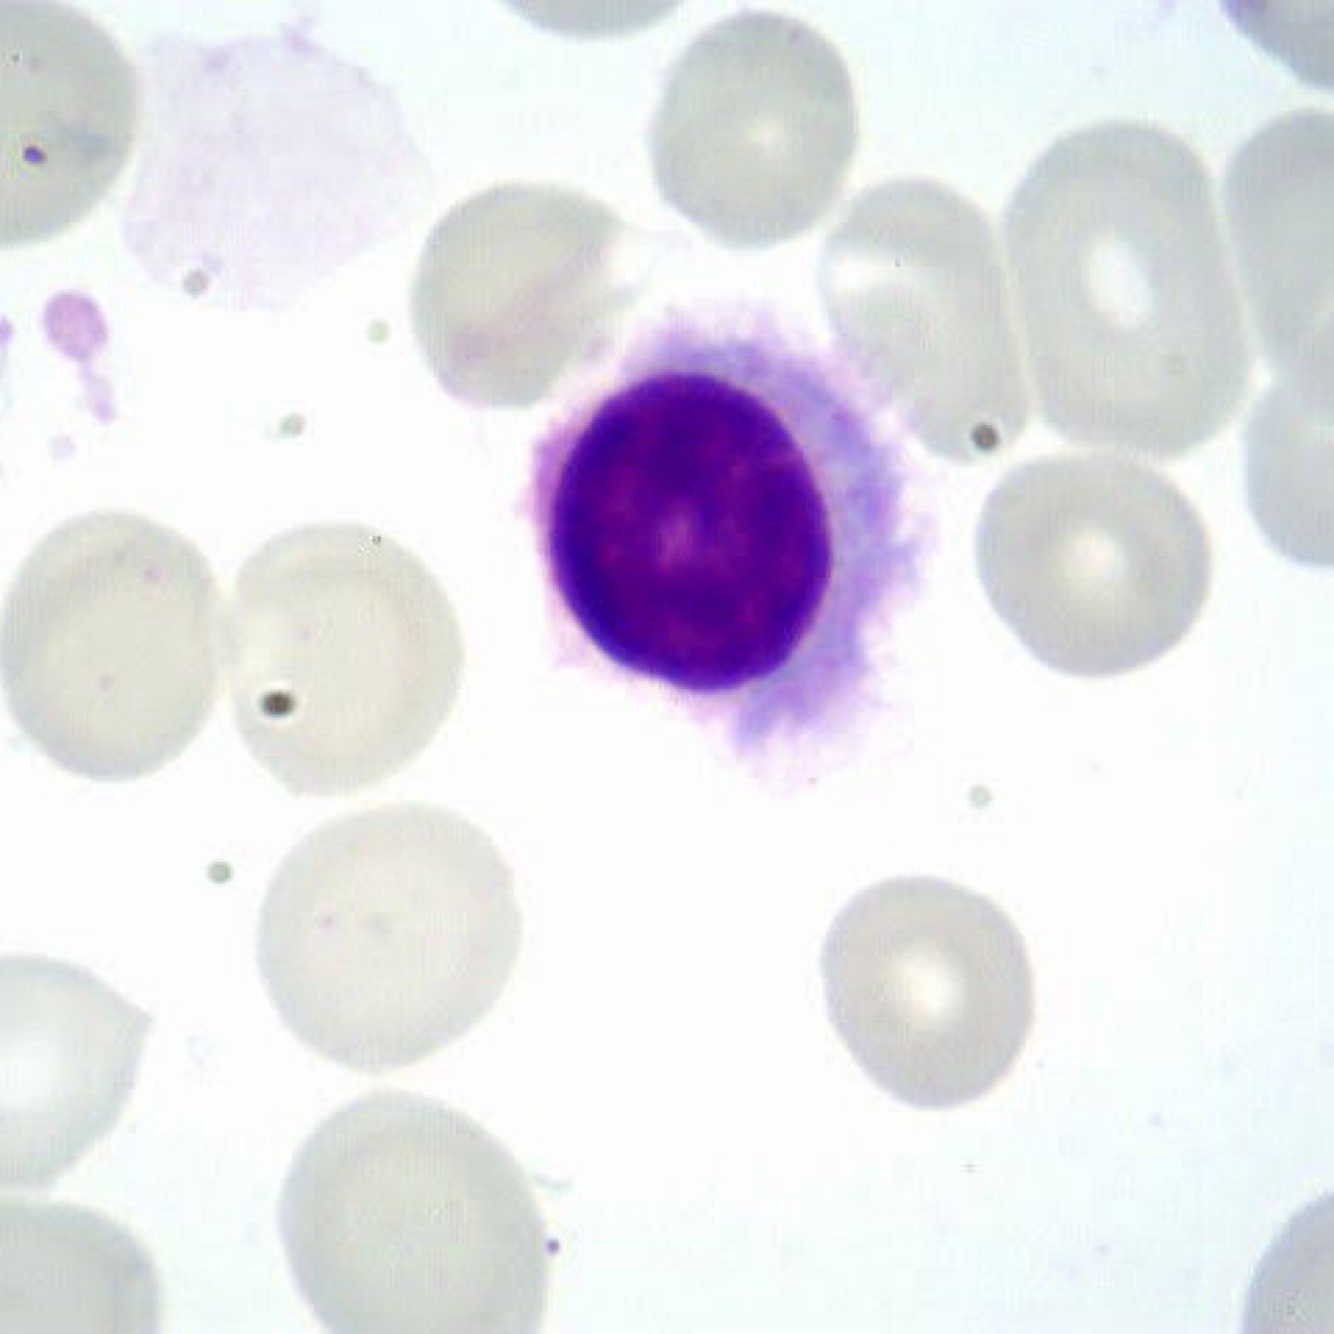
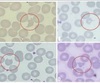
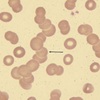

Qual achado?
Associada a qual diagnóstico?

Dermatite herpertiforme
Associada a doença celíaca

Célula de Mott (mieloma múltiplo)
(Núcleo lateralizado, com complexo de Golgi evidente (parte mais branca no citoplasma, logo ao lado do núcleo))

Linfoma de burkitt (citoplasma vacuolizado)
Plasmodium vivax (malária)

Hemofagocitose

Flower cell - leucemia T relacionada ao HTLV
Leishmaniose
(Macrófago com um monte de bicho dentro)

Histoplasmose capsulatum ( cápsula proeminente)

Célula de cezary (“dobrada, sobreposta”)
Linfoma cutâneo de células T

Linfoma do Manto (endentações nucleolares)
Síndrome mielodisplasica (blastos, peugher huet, eritroblasto)
Qual achado?
Associado a qual diagnóstico?
Dacriócitos
Mielofibrose
Qual achado?
Associado a qual diagnóstico?

Bastonetes de Auer
LMA / LPA
(Blastos grandes, com nucléolos (áreas mais brancas dentro do núcleo), com grande quantidade de grânulo (chegando a fazer bastonete de Auer), com bastante citoplasma).
Qual achado?
Associado a qual diagnóstico?
MANCHAS DE GRUMPECHT
LLC
Grumpecht = células estouradas
Qual achado?
Associado a qual diagnóstico?
BLASTO LINFOIDE
LLA
Blastos menores que os mieloides, com menos citoplasma, sem grânulos
Qual achado?
Associado a qual diagnóstico?
NEUTROFILO HIPERSEGMENTADO
Deficiência de vitamina B12
Diagnóstico ?
CHEDIAK HIGASHI
Qual achado?
Diagnóstico?

HEMÁCIA EM FOICE / DREPANÓCITO
ANEMIA FALCIFORME
Achado?
Diagnóstico?

REED STERNBERG
LINFOMA HODGKIN
Achado?

AGREGADO PLAQUETÁRIO
Lembrar que é uma causa de pseudo-plaquetopenia
Achado?
Diagnóstico?
HEMÁCIA EM ALVO
HEMOGLOBINOPATIA
Achado?
Diagnóstico?

CORPÚSCULO DE HOWELL JOLLY
PÓS-ESPLENECTOMIA
Diagnóstico?
ESTOMATOCITOSE
Diagnóstico?
TRICOLEUCEMIA
Células “cabeludas”
Lembrar que no enunciado vai ter uma super esplenomegalia Alteração de hemograma mais característica: monocitopenia